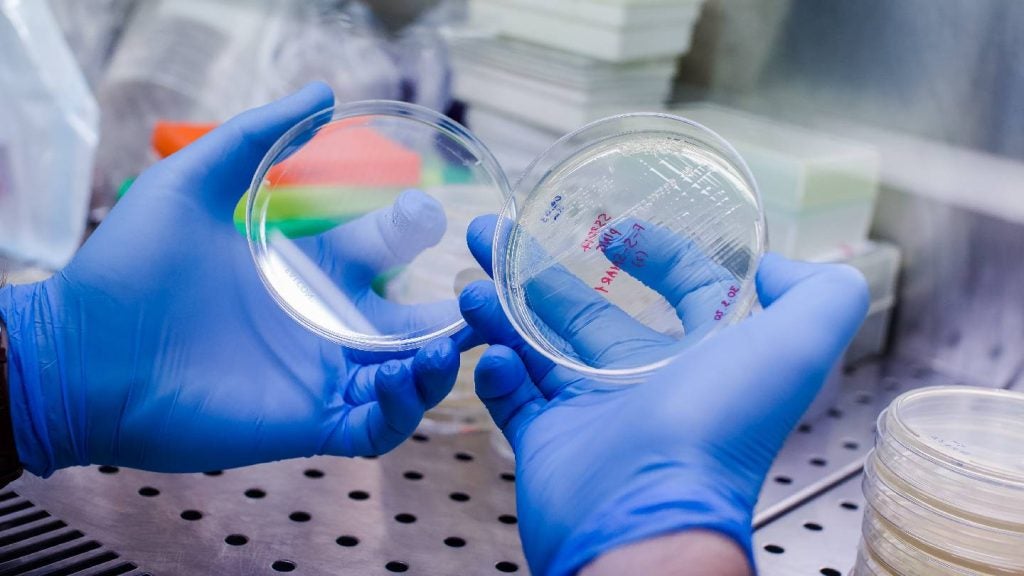

All articles by Vidya Sagar Maddela
Amgen announces $900m expansion of Ohio manufacturing facility
The Ohio expansion, which is expected to create 750 jobs, is set to further strengthen the company’s global biomanufacturing network, building on its operational expertise and technological advancements
Pfizer’s sasanlimab plus BCG shows promise in bladder cancer
In the Phase 3 trial, the combination showed a 32% reduction in the risk of disease-related events, high-grade disease recurrence or progression, which is the primary endpoint
PTC Therapeutics Receives Positive CHMP Opinion for Sephience™ (sepiapterin) for the Treatment of Children and Adults Living with Phenylketonuria (PKU)
PTC is a global biopharmaceutical company that discovers, develops and commercializes clinically differentiated medicines that provide benefits to children and adults living with rare disorders
Tempus partners with AstraZeneca and Pathos for oncology AI model
The partnership aims to leverage Tempus’ AI capabilities and oncology data to generate biological and clinical insights, discover novel drug targets, and develop cancer therapeutics.
Repertoire, Genentech partner to develop T cell-targeted therapies
Repertoire will use its DECODE platform to identify new targets, and Genentech will focus on preclinical and clinical development, and global commercialisation of the therapies
Latest update on U.S. FDA BLA for Novavax’s COVID-19 Vaccine
We have recently received formal communication from the FDA in the form of an information request for a postmarketing commitment (PMC) to generate additional clinical data
TNF Pharma, Renova collaborate on AI-powered drug development
The collaboration aims to identify high-risk patients who could benefit from preserving lean muscle mass during GLP-1 treatment for diabetes, weight loss, and weight management.
ConcertAI and Bayer partner to enhance precision oncology
The partnership aims to advance clinical development in precision oncology, using ConcertAI’s new Translational360 platform, a comprehensive clinical molecular database.
FDA grants Breakthrough Therapy Designation for BrainChild Bio’s B7-H3 CAR T-cell therapy for incurable pediatric brain tumors
Breakthrough Therapy Designation is based on the encouraging survival data from the Phase 1 BrainChild-03 trial in children and young adults with diffuse intrinsic pontine glioma (DIPG)
Ono Pharma, Jorna Therapeutics collaborate on RNA-editing drugs
Jorna will use its advanced AI model, SkyEngine, to design RNA editing drug sequences, while Ono holds exclusive rights to discover, develop, and commercialise the RNA therapeutics